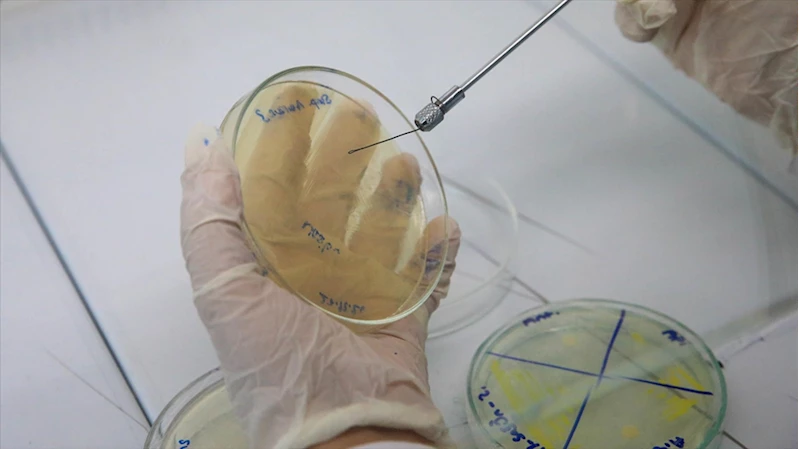

Erkek arı larvasının bakteriler üzerinde antibiyotik etkisi gösterdiği belirlendi
Erkek arı larvasının bakteriler üzerinde antibiyotik etkisi gösterdiği belirlendi
UŞAK (AA) - Üniversitede, Ziraat Fakültesi Zootekni Bölümü Öğretim Üyesi Prof. Dr. Nuray Şahinler öncülüğünde yaklaşık 1 yıl önce erkek arı larvasının bakteriyel hastalıklar üzerindeki etkisine ilişkin çalışma başlatıldı.
Bu kapsamda meme başı iltihabı olduğu tespit edilen ineklerden alınan sütler üniversitenin laboratuvarında izole edildi, sütlerdeki bakteriler türüne göre ayrıştırıldı. Gelişimi engellenmek istenen bakterilerin bir kısmına antibiyotik bir kısmına da krem haline getirilmiş apilarnil uygulandı. Çalışma sonucunda erkek arı larvası uygulanan bakterilerde de antibiyotik uygulananlara eş değer sonuç alındı.
14 bakteri türünde etkiliLaboratuvar ortamında yapılan çalışmalarla, erkek arı larvasının, canlılarda sağlığı olumsuz etkileyen 14 bakteri türünde benzer sonuçlar verdiği, antibiyotikler gibi hem bakterilerin çoğalmasını engellediği hem de yok ettiği belirlendi.
Prof. Dr. Nuray Şahinler, AA muhabirine, 25 yıldır arı ürünleriyle ilgili çalışmalar yürüttüğünü söyledi.
Arı ürünlerinin antioksidan ve probiyotik özelliklerinin bilindiğini anlatan Şahinler, son yıllarda genelde arı zehri ile ilgili çalışmalar yapıldığını kaydetti.
Şahinler, sadece çiftleşme için ihtiyaç duyulan erkek arı larvasının daha sonra arıcılar tarafından kovanlardan toplanarak atıldığını, 7 ila 10 günlük erkek arı larvası apilarnilin arıcılar tarafından atık olarak görüldüğünü aktararak, oysa apilarnilin yetişkin bir insanın ihtiyaç duyduğu bütün besin maddelerine sahip olduğunu söyledi.
Laboratuvar ortamında bakteriler üzerinde bir grupta antibiyotik bir grupta arı zehri bir grupta apilarnilin etkisini test ettiklerini dile getiren Prof. Dr. Şahinler, "Aynı zamanda herhangi bir antibiyotik, arı zehri ya da apilarnil olmayan kontrol grubumuz da vardı. Kontrol grubunda bütün bakterilerin petriyi (laboratuvar kabı) kapladığını, üremenin geliştiğini görürken, diğer gruplarda hem antibiyotikte hem apilarnilde hem de arı zehrinde herhangi bir gelişmenin olmadığını, bakterilerin gelişimini inhibe (engellemek) ettiğini belirledik. Araştırma sonucunda antibiyotiğe eş değer çok güzel sonuçlar gördük." diye konuştu.
Çalışmanın önemiŞahinler, son yıllarda dünyada antibiyotik direnci risklerinin sıklıkla dillendirildiğine değinerek, sözlerini şöyle sürdürdü:
"Günümüzde antibiyotik direnci gündemde olan bir konu. 15-20 yıl içinde artık bakteriyel hastalıkların tedavi edilemeyecek hastalıklara dönüşeceğini, çok yoğun ve bilinçsiz antibiyotik kullanımına bağlı olarak bakterilerin mutasyonla beraber antibiyotik direnci geliştirdiğini biliyoruz. Bu konu gerçekten çok önemli. Ülkemiz dünyada antibiyotik kullanımında ilk üç sırada. Çok yoğun antibiyotik kullanımına bağlı olarak bizim ülkemizde de maalesef ki antibiyotik direncinin geliştiğini söyleyebiliriz. Dolayısıyla antibakteriyel aktivitesi olan bu ürünlerin antibiyotiklere eş değer etkinliklerinin bulunması anlamlı."
Erkek arı larvalarının, doğal olarak tüketilmesinde dozajının önemli olduğunu, aşırı kullanımının zararlı olacağını belirten Şahinler, ilaç formuna dönüşebilmesi için 4 fazın daha tamamlanması gerektiğini sözlerine ekledi.
Muhabir: Mehmet Çalık
Irak, elektrik üretimi için İran'dan gelen gaz akışının tamamen durduğunu açıkladı
Cumhurbaşkanı Erdoğan, "Şüheda 1915" Tiyatro Gösterimi'ni izledi
Sanayi ve Teknoloji Bakanı Kacır: GÖKBEY, sivil yolcu taşıma sertifikasyonunu tamamlayan ilk milli hava aracımız oldu
ABD'de üretici enflasyonu şubatta beklentileri aştı
Merkez Bankası Para Politikası Kurulu Toplantı Özeti yayımlandı
Hakkari'de beyaz örtüyle kaplı dağlardaki kar manzarası dronla görüntülendi
UEFA Konferans Ligi'nde çeyrek finalistler yarın belli olacak
Suriyeli Abdülbari için 15 yıldır sakladığı evinin anahtarı "umudun başlangıcını" simgeliyor
Eminönü'nde bayram alışverişi hareketliliği
Diyarbakır'da "bayramda sofralar tatlansın" diye kadayıf üreticilerinden vardiyalı çalışma
Trump, Hürmüz Boğazı'nı ele geçirmeleri halinde "müttefiklerinin harekete geçeceğini" savundu
Almanya'daki Müttefik Hava Komutanlığınca görevlendirilen patriot sistemi Adana'da konuşlandırılıyor
ABD Başkan Yardımcısı Vance'in İran'a yönelik saldırılar konusunda sessiz kalması dikkati çekiyor
73 ildeki uyuşturucu operasyonlarında 958 şüpheli yakalandı
Trabzon'da terzi kardeşlerin ömrü dikiş makinesinin başında geçti
Milli futbolcu Kenan Yıldız: 4 yıldır buradayım ve burası bana büyük güven gösterdi
Afrika Uluslar Kupası şampiyonluğu iptal edilen Senegal kararı tahkime taşıyacak
Sakıp Sabancı Müzesi Resim Koleksiyonu yenilenen seçkisiyle açıldı
Özbek aileler ramazanda "ağız açar" iftar sofralarında bir araya geliyor
Depremzede anne, Türk Kızılay gönüllüsü olarak kız çocuklarına bayramlık dikti
Baharın müjdecisi leylekler Tunceli'deki köylerde bulunan yuvalarına dönmeye başladı
Kanoyla suda değil, Erciyes'te kar üzerinde süzüldüler
Hatay'da meslek liselilerin ürettiği çikolatalar bayramda ağızları tatlandıracak
Çanakkale Savaşları'nın bilinmeyen yönleri, Hisart Canlı Tarih Müzesi'nde sergileniyor
Kız kardeşler hayallerini sanat atölyesinde gerçeğe dönüştürdü
Sezonda 200 bin kişiyi ağırlayan Davraz Kayak Merkezi bayramı da hareketli geçirecek
"Saygınlar Kulübü" 65 yaş üstündekilerin buluşma adresi oldu
Kastamonu'da şehit öğretmen ve öğrencilerin hatıraları sınıftaki müzede yaşatılıyor
Tescilli Antep baklavasında üretim bayram için iki katına çıktı
SHURA'ya göre enerji güvenliği için ithal kaynak azaltılmalı, yenilenebilir yatırımları artırılmalı
Yükleniyor






